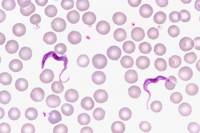
Protozoaires

La parasitologie est la science qui étudie les organismes parasites (animaux, végétaux, champignons ou fungi), ainsi que les maladies qu'ils génèrent chez l'Homme, les animaux ou les plantes.
On considère comme parasite un être vivant animal, un champignon (règne des Fungi) et plus rarement un végétal (Ex : Gui, Cuscute) qui vit pendant tout ou partie de son existence une vie aux dépens d'un autre organisme, qualifié d'hôte. Si certains parasites sont facultatifs, la plupart sont obligatoires, le parasite ne parvenant à se développer que sur ou dans le corps d'un hôte souvent spécifique. L'association hôte-parasite, ou parasitisme, est une relation à sens unique, qui ne bénéficie qu'au parasite, tout en étant préjudiciable à l'hôte, lequel peut finir par mourrir de la relation.
Les parasites externes, ou ectoparasites, s'installent à la surface de leur hôte pour y prélever de la nourriture, de façon temporaire (moustiques, mouches piqueuses,...) ou permanente (poux, gui). Leur corps a une morphologie peu spécifique, et un appareil buccal particulier leur permet de prélever du liquide, généralement du sang, sur l'hôte (parasites hématophages). Chez les végétaux, les parasites courants développent un suçoir destiné à prélever un liquide, la sève, pour obtenir leurs aliments.
Les parasites internes, ou endoparasites, vivent à l'intérieur du corps de leur hôte, et y prélèvent des éléments nutritifs, tout en profitant d'un environnement (biotope) propice à leur développement. L'organisme parasite présente parfois une modification importante de sa morphologie et de sa physiologie par rapport aux autres espèces de son groupe taxonomique.